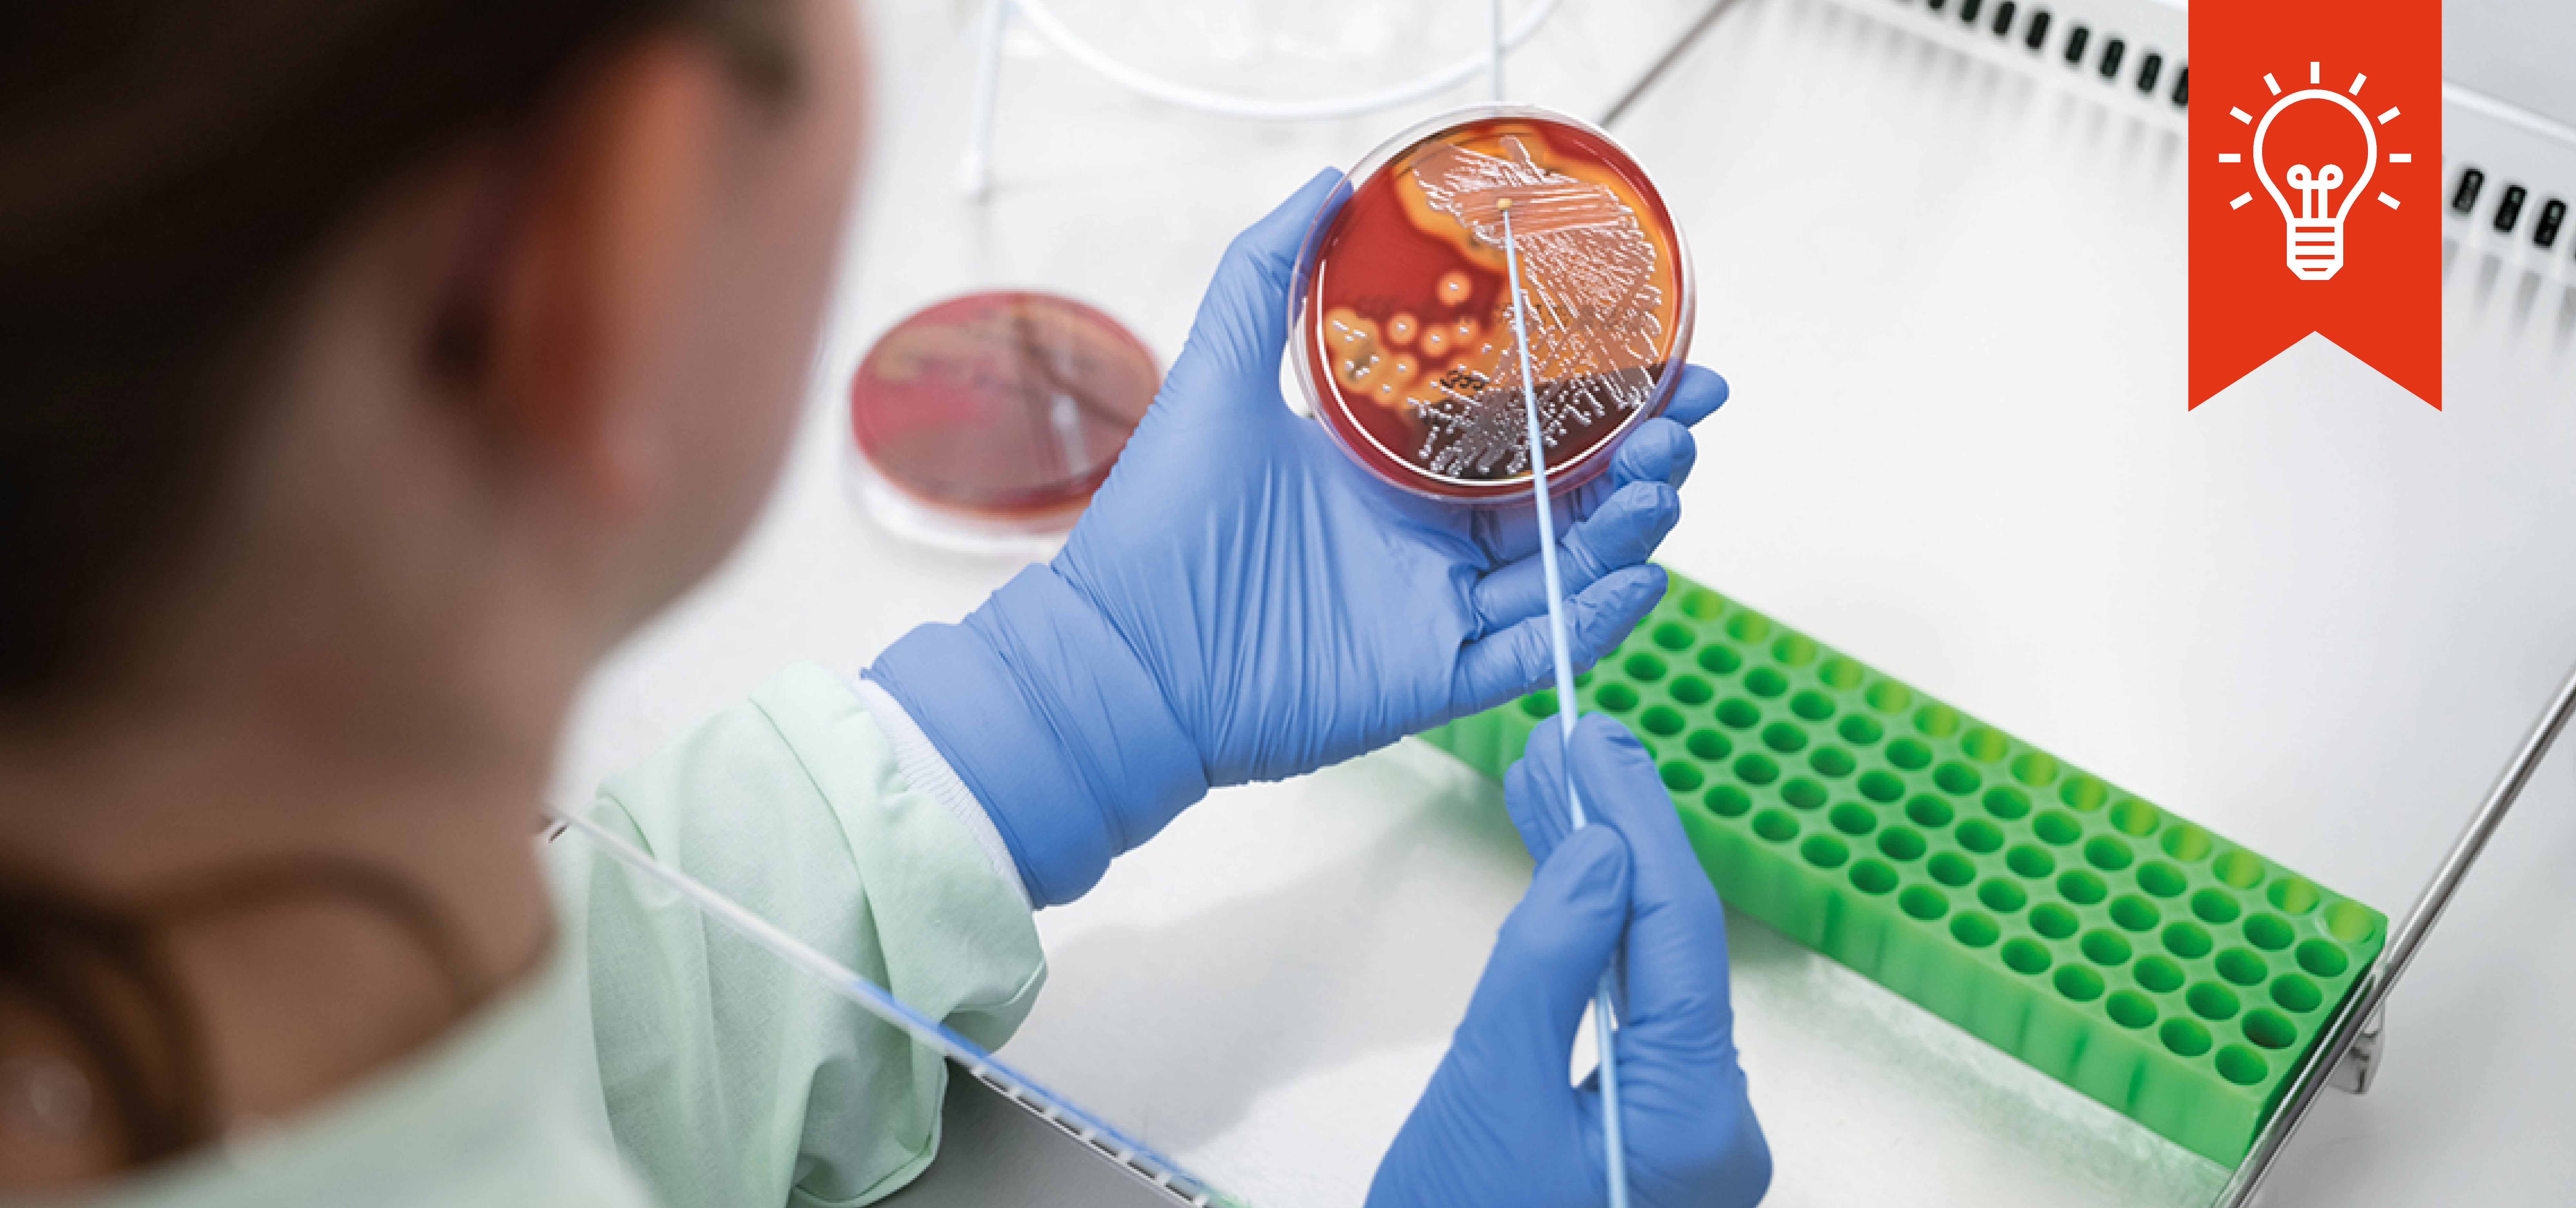

Industriegebiet Eisenach-Kindel
Vom Militärgelände zum Zukunftsstandort: Nach dem Abzug der russischen Streitkräfte wurde der ehemalige Truppenübungsplatz Eisenach-Kindel neu gedacht. Große Teile gingen an den Nationalpark Hainich, während andere Flächen zu einem modernen Industriestandort mit Verkehrslandeplatz entwickelt wurden - heute Heimat von rund 10 Unternehmen.